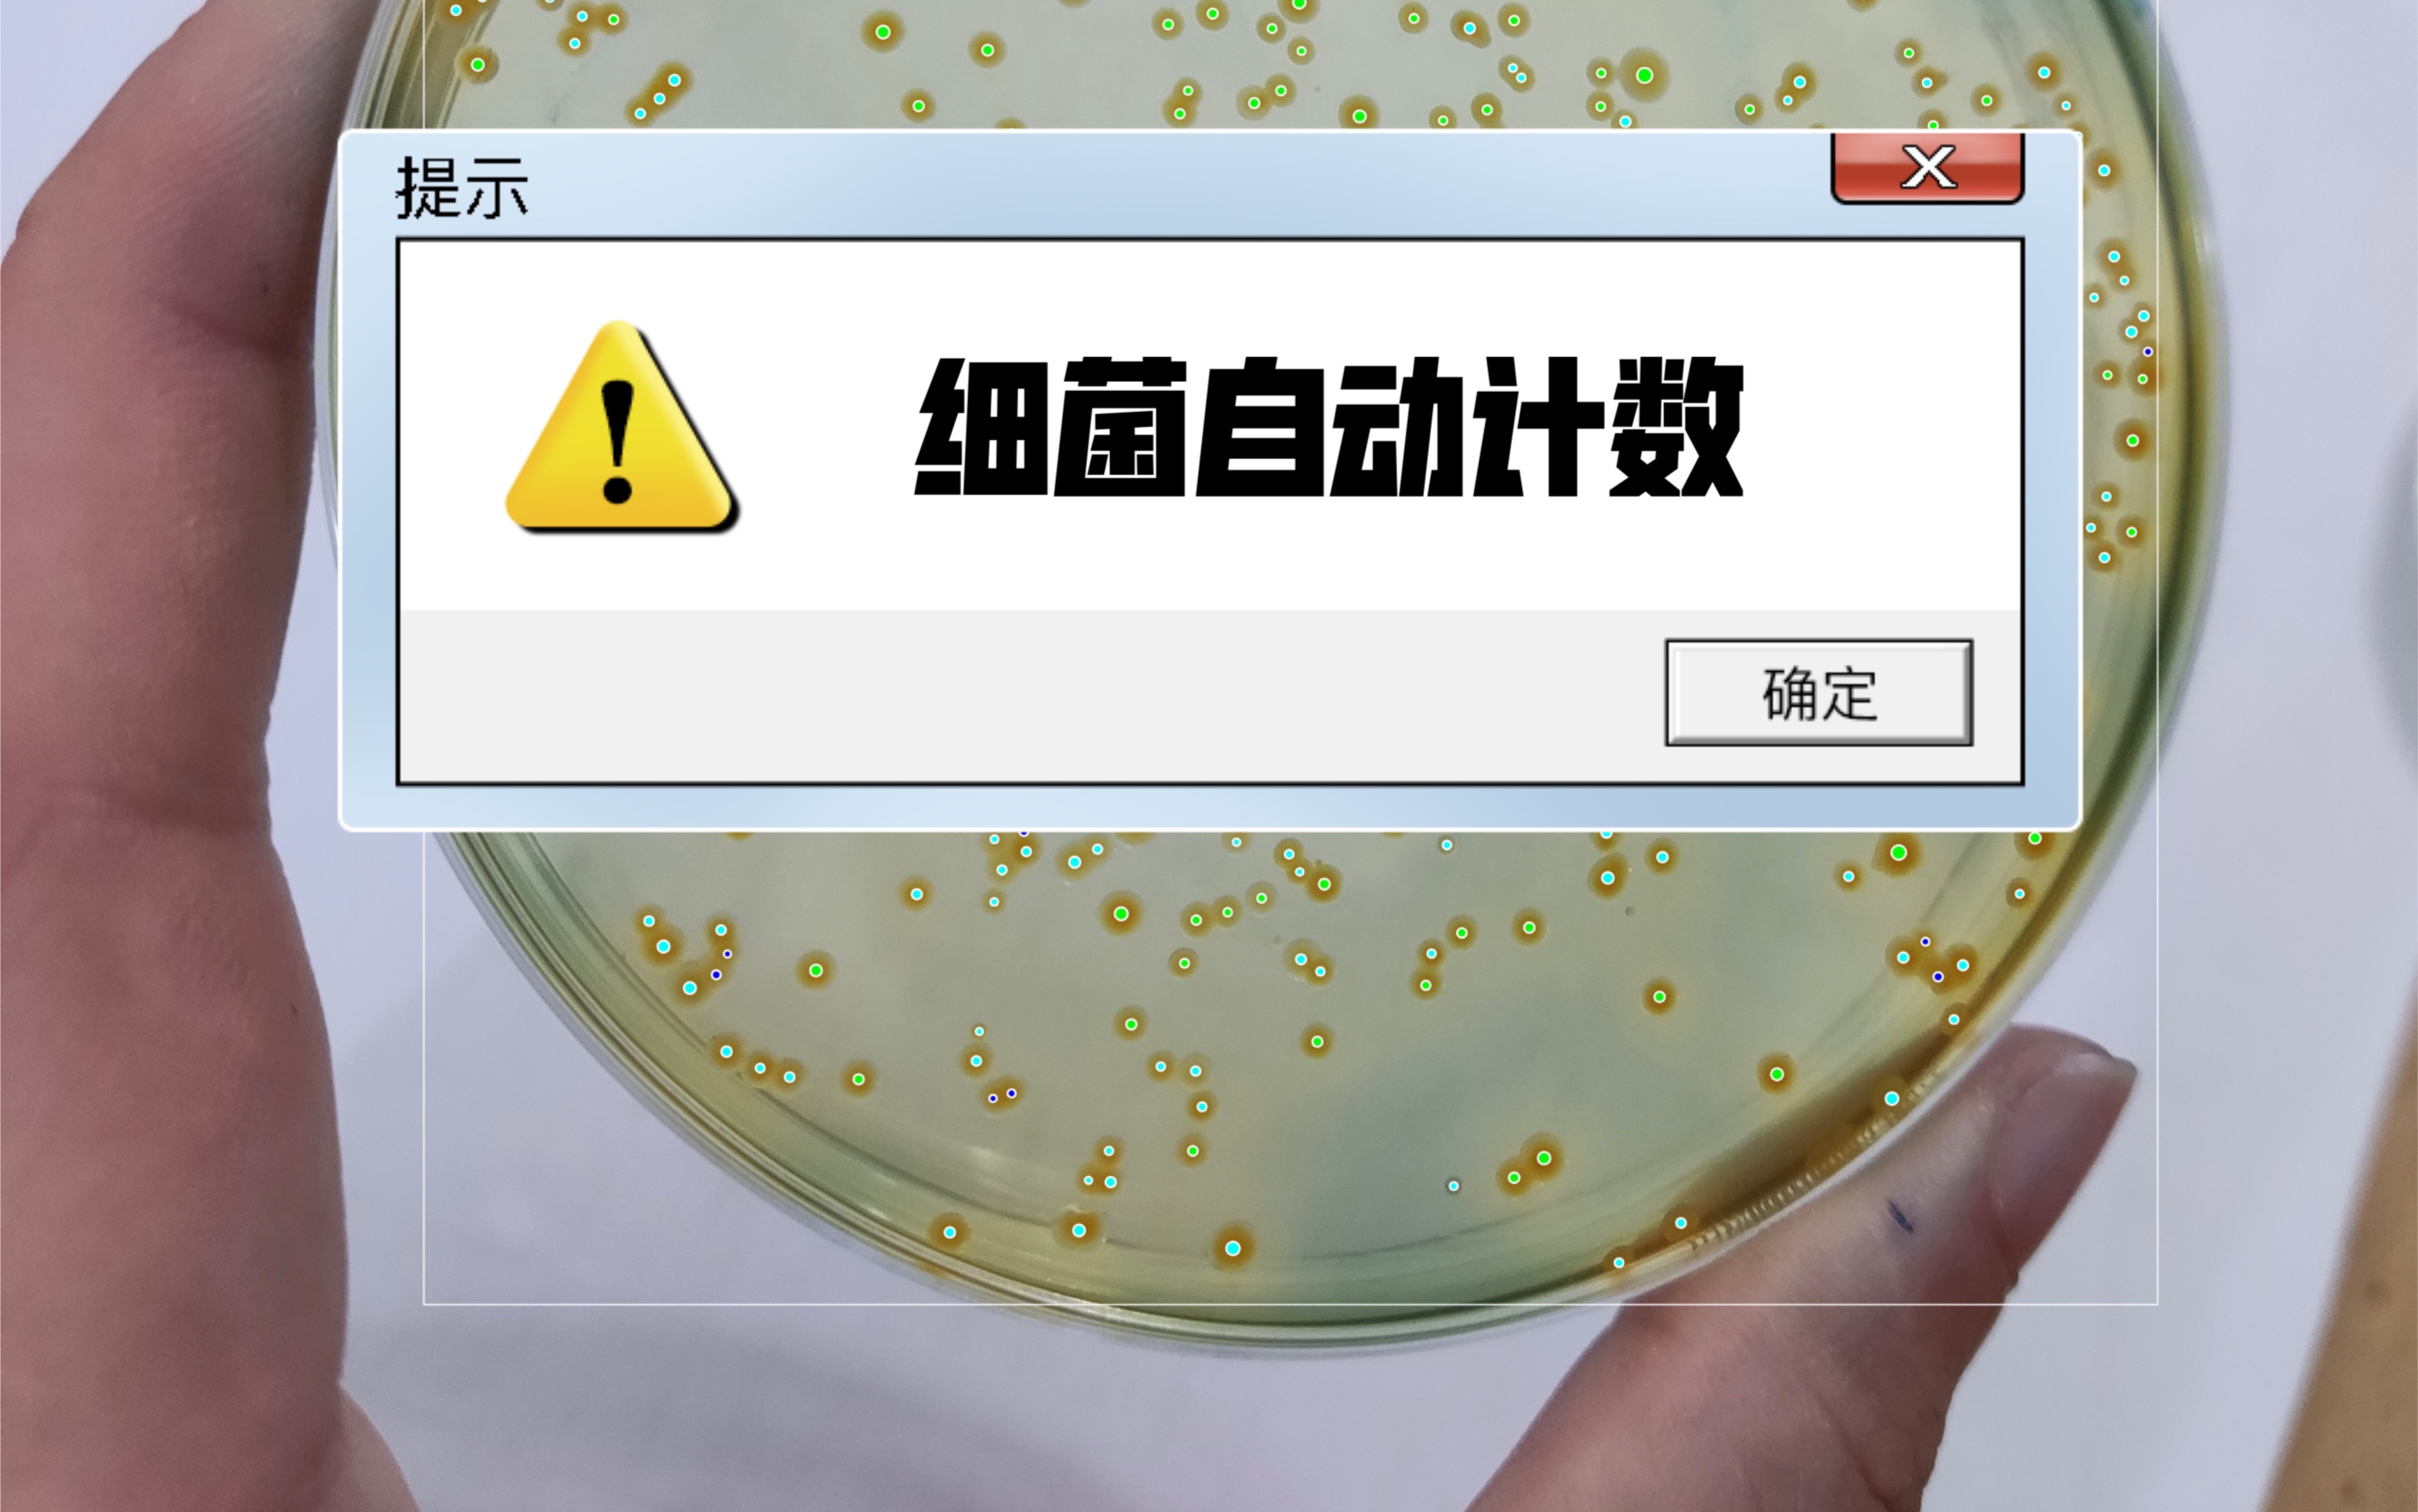
细菌菌落自动计数你是手动计数还是自动计数呢科研日常好帮手工具推荐

细菌计数

水中细菌总数及大肠菌群的测定——万融实验
图片尺寸471x391
细菌数量测定---标准平板计数法ppt
图片尺寸1080x810
全自动菌落计数仪器
图片尺寸500x272
微生物学实验技术:水中细菌学检查
图片尺寸937x459
数显菌落计数器 器实验室细菌计数器 数量测试含探
图片尺寸800x800
大肠埃希氏菌计数
图片尺寸1190x1684
数智化升级微生物检测掀起菌落计数新革命
图片尺寸2113x949
实验室显微镜用细菌记数板生物血盖片细胞计数板血细胞计数板计数载
图片尺寸800x800
细菌菌落自动计数你是手动计数还是自动计数呢科研日常好帮手工具推荐
图片尺寸3134x1960
食品中大肠菌群的计数方法
图片尺寸532x547
表10-1 计算细菌菌落总数方法的示例菌落计数报告,菌落数在100以内按
图片尺寸1760x656
bd800全自动影像分析菌落计数仪全自动菌落计数器细菌分析系统专业
图片尺寸1215x598
检测方法 化妆品中菌落总数检验方法
图片尺寸570x256
自动计数培养皿中细菌菌落
图片尺寸1080x810
细胞计数血球计数板法你还不快收藏
图片尺寸1080x1440
幼儿园传染病发病统计表
图片尺寸2526x1785
请教微生物计数问题
图片尺寸3456x2182
细胞计数板上的细胞是什么样子的,计数时,该数什么样的呢?
图片尺寸602x402
菌落总数计数问题
图片尺寸627x453
显微镜用实验室细菌记数板生物盖片细胞细胞计数载玻片球 球计数板(1
图片尺寸800x800